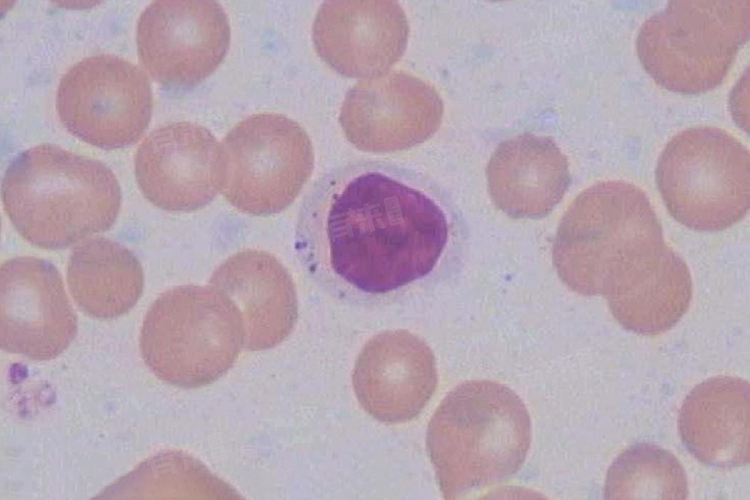

免疫细胞是指参与免疫应答或与免疫应答相关的细胞,具有免疫防御、自稳、监视和调节等多种作用,临床应用广泛。
1、免疫细胞的基本分类
- 淋巴细胞:包括T细胞、B细胞等,是免疫应答中的关键细胞。T细胞主要负责细胞免疫,能够识别并直接杀伤被感染的细胞或癌细胞;B细胞则主要负责体液免疫,通过产生抗体来中和病原体。
- 自然杀伤细胞(NK细胞):能够直接杀伤某些肿瘤细胞或病毒感染的细胞,是机体非特异性免疫的重要组成部分。
- 单核-巨噬细胞:包括血液中的单核细胞和组织中的巨噬细胞。它们具有吞噬和杀伤病原体、清除凋亡细胞及碎片、递呈抗原等多种功能。
- 粒细胞:如中性粒细胞、嗜酸性粒细胞和嗜碱性粒细胞等,其中中性粒细胞在急性感染中起重要作用,能够吞噬和杀灭病原体。
- 肥大细胞:主要存在于与外界接触的组织中,如皮肤、呼吸道等,能够释放多种介质参与免疫反应。
2、免疫细胞的主要作用
- 免疫防御:免疫细胞能够识别和清除外来的病原体,如细菌、病毒等,防止其侵入机体并引发疾病。这是免疫细胞最基本的防御功能。
- 免疫自稳:免疫细胞能够清除体内衰老、凋亡的细胞及细胞碎片,维持机体内环境的稳定。同时,它们还能够调节免疫系统的功能,防止过度反应或自身免疫病的发生。
- 免疫监视:免疫细胞能够识别和清除体内突变的细胞,如肿瘤细胞等,防止其发展为恶性肿瘤。这一功能对于预防肿瘤的发生具有重要意义。
- 免疫调节:免疫细胞通过分泌各种细胞因子和趋化因子等,调节其他免疫细胞的活性和功能,从而协调整个免疫系统的应答过程。这使得免疫系统能够根据不同的情况做出快速而准确的反应。
随着生物技术和医学研究的不断进步,免疫细胞在临床上的应用也越来越广泛。例如,免疫细胞疗法通过激活或增强患者自身的免疫细胞功能来治疗肿瘤等疾病;干细胞移植则利用干细胞的分化和再生能力来治疗多种细胞损伤和免疫系统疾病。这些应用为许多原本难以治疗的疾病提供了新的希望。

